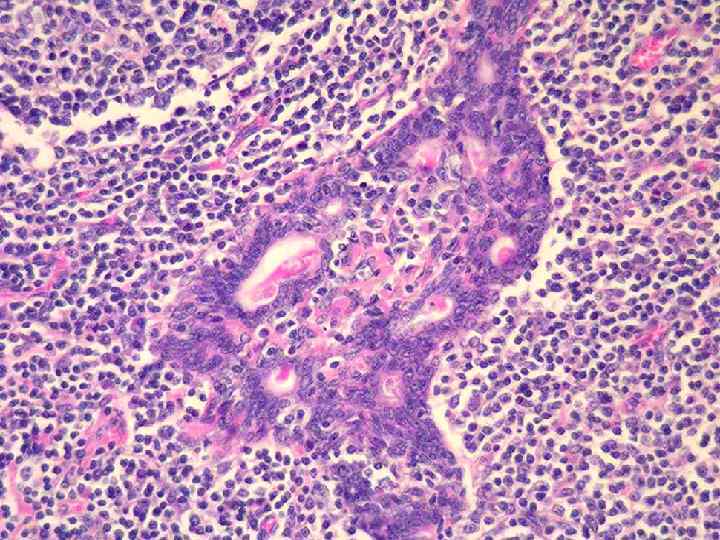
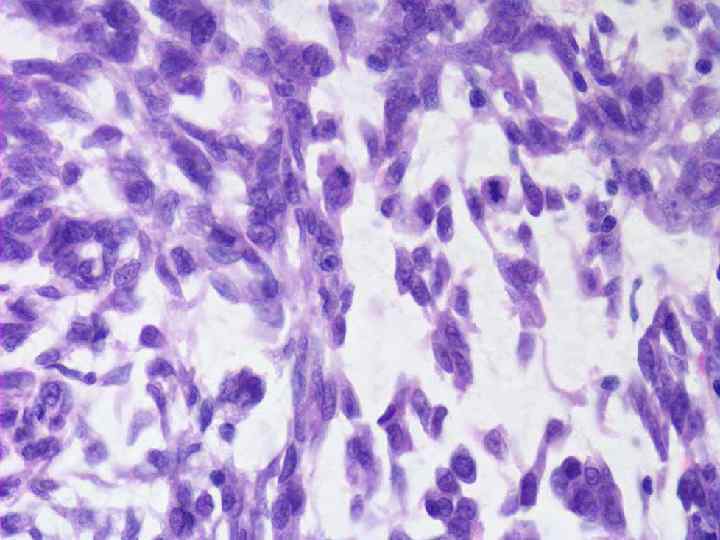
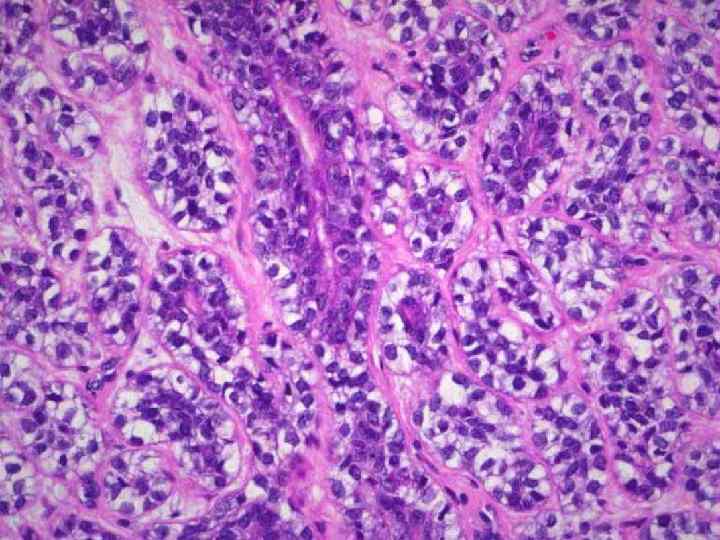
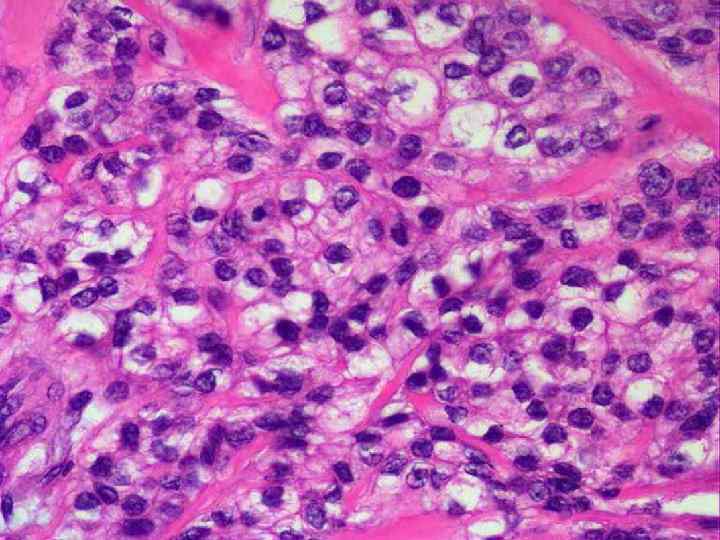

Лекция болезни слюнных желез Литвинов.pptx
- Количество слайдов: 117

Болезни слюнных желез

Содержание Пороки развития Сиалоадениты Сиалолитиаз Аутоиммунные поражения слюнных желез Кисты слюнных желез Опухолеподобные поражения слюнных желез • Опухоли слюнных желез • • •

Пороки развития слюнных желез Аплазия Гипоплазия Эктопия (дистопия, гетеротопия) Атрезия протоков Аномальные ветвления Дефекты стенок протоков (врожденные фистулы) • Смещение устья протоков • • •


Сиалоаденит • Первичный, вторичный (чаще) • Интрадуктальный, лимфогенный, гематогенный • Околоушные (паротит), поднижнечелюстные, подъязычные (редко) • Вирусный, бактериальный, грибковый

Эпидемический паротит • Острое инфекционное заболевание с развитием местных воспалительных изменений, преимущественно в интерстиции околоушных слюнных желез • Чаще мальчики от 5 до 10 лет • Характерны эпидемические вспышки в ограниченных районах

Эпидемический паротит • Возбудитель – РНК вирус • Путь передачи – воздушно-капельный или контактный • Входные ворота – слизистая полости рта • Размножение вируса в слюнных железах и выделение его со слюной • Протекает 1. 5 недели, оставляя стойки иммунитет

Патологическая анатомия Макро- Микро- • Резкое увеличение обеих околоушных желез • Тяжелая белковая дистрофия клеток ацинусов и протоков • Серозно-фибринозное воспаление в интерстиции • Лимфогистиоцитарная инфильтрация



Осложнения • • Орхит Оофарит Серозный менингит Панкреатит

Цитомегаловирусный сиалоаденит • Вирусная инфекция с преимущественным поражением ацинарных клеток выводных протоков и межуточной ткани слюнных желез • Поражает детей раннего возраста • Возбудитель ДНК-вирус группы герпеса

Патологическая анатомия Макро- Микро- • Увеличение слюнных желез • Клетки ацинусов и протоков с увеличенными ядрами «совиный глаз» • Лимфогистиоцитарная инфильтрация стромы


Исходы • Склероз околоушной железы! • Переход в генерализованную форму с поражением внутренних органов

Гриппозный сиалоаденит • Возникает как вторичный при тяжелых формах гриппа • Поражает несколько слюнных желез • Исходы, как правило, благоприятные

Патологическая анатомия Макро- Микро- • Плотные инфильтраты в слюнных железах • Тяжелая дистрофия эпителия ацинусов и протоков • Серозно-фибринозное воспаление в интерстиции • Лимфогистиоцитарная инфильтрация • Гиперплазия лимфойдных фолликулов


Осложнения • • Гнойное воспаление с абсцедированием Флегмона Гнилостное воспаление Гангренозное воспаление


Острые бактериальные сиалоадениты • Протоки слюнных желез в норме стерильны • Местные факторы: травмы, опухоли, камни, рубцы • Общие факторы: иммунодефициты, сахарный диабет, сердечно-сосудистые заболевания • Пути проникновения возбудителя: интраканикулярный, лимфогенный, гематогенный, контактный

Патологическая анатомия Макро- Микро- • Резкое увеличение слюнных желез • Серозный • Гнойный • Гангренозный

Исходы • Абсцессы • Флегмона • Эрозии крупных сосудов • Сепсис

Хронический сиалоаденит • Чаще околоушные железы • Чаще вторичный (инфекции, травмы, пороки) • Ремиссии и обострения обусловлены циркуляцией провоспалительных цитокинов!

Патологическая анатомия Макроскопические изменения желез: • Гладкие • Плотно-эластические • Не спаяны • Тестовидная консистенция при обострении


Микроскопические изменения Интерстициальный продуктивный Протоковый (сиалодохит Куссмауля) • Очаговые или диффузные лимфогистиоцитарные инфильтраты • Разрастание грубоволокнистой ткани • Атрофия протоковых структур • Микроабсцессы при обострении • Диффузная полиморфноклеточная инфильтрация между протоками • Расширение междольковых протоков • Склеротические изменения выражены слабо


Исходы хронических сиалоаденитов Редкие рецидивы Частые рецидивы • Цирроз железы • Кистозное перерождение

Туберкулезный сиалоаденит • Первичный туберкулез с поражением слизистой полости рта • Гематогенная форма прогрессирования первичного туберкулеза • Генерализованная форма гематогенного туберкулеза • Образование милиарных и крупных очагов



Актиномикоз • Актиномицеты – «лучистые грибы» • Бактерии (!) – вызывают также в ассоциации с другими возбудителями кариес • Условия для развития – снижение неспецифической защиты организма • Входные ворота – кариозные зубы, травмы слизистой, протоки слюнных желез

Патологическая анатомия • Сочетание экссудативных и продуктивных проявлений • Актиномикотические гранулемы • Формирование абсцессов • Перенос макрофагами фрагментов мицелия в окружающие ткани • Формирование вторичных гранулем контактным, лимфогенным и гематогенным путем



Сиалолитиаз • Образование конкрементов в ацинусах и протоках слюнных желез • Чаще болеют мужчины • В 90% случаев поднижнечелюстная железа

Этиология и патогенез • Дискинезия, сдавление протоков, инородные тела • Увеличение в слюне белков, фосфатов и карбонатов кальция • Кристаллизация солей на белковом матриксе с формированием конкрементов • Хронический калькулезный сиалоаденит • Увеличение конкрементов за счет богатого белком воспалительного экссудата


Патологическая анатомия Макро- Микро- • Камни размером от 1 -2 мм до 1. 5 см в протоках или ацинусах • Картина диффузного интерстициального сиалоаденита • Расширение протоков • Склероз стромы • Регенерационная гипертрофия в сохранившихся дольках




Исходы • Цирроз железы с нарушением функции • Абсцедирование • Флегмоны

Аутоиммунные поражения слюнных желез • • Активный хронический вирусный гепатит Струма (зоб) Хашимото Синдром Шегрена Синдром Микулича

Синдром Шегрена • Ксеростомия • Ксероофтальмия • Полиартрит Может быть при других аутоиммунных заболеваниях Чаще болеют молодые женщины

Этиология • Носительство HLA-B 8, HLA-DR 3 • Возможно лимфотропные вирусы

Патологическая анатомия Макро- Микро- • Увеличение, уплотнение желез • Тяжелая дистрофия эпителия ацинусов и протоков • Очаговая лимфогистиоцитарная инфильтрация (CD 4+, CD 20+)

Синдром Микулича (доброкачественное лимфоэпителиальное поражение) • Поражение больших и малых слюнных и слезных желез • Поражения суставов не наблюдается! • Массивная лимфогистиоцитарная инфильтрация с атрофией ацинарных отделов • Возможен исход в злокачественную лимфому!



Исходы аутоиммунных сиалоаденитов • Атрофия и склероз железы • Снижение или полное выключение функции железы

Кисты слюнных желез • Чаще малые железы • Этиология: травма выводного протока, пороки развития, сиалоаденит, сиалолитиаз, оперативные вмешательства • Ретенционные и слизистые кисты

Ретенционная киста Макро- Микро- • Шаровидное возвышение • Под слизистой полости рта • Флюктуирует • Соединительная ткань, выстланная уплощенным эпителием • Содержимое прозрачное или гной при инфицировании



Слизистая киста Макро- Микро- • Вид опухоли • При удалении частые рецидивы • Тонкая соединительнотканная капсула • В просвете слизистые клетки и слизь


Киста подъязычной слюнной железы • Ранула «лягушачья опухоль» • Переднебоковой отдел дна полости рта, вблизи уздечки языка • Связана с подъязычной слюнной железой


Реактивные опухолеподобные поражения слюнных желез • Доброкачественное лимфоэпителиальное поражение (синдром Микулича) • Сиалоз • Онкоцитоз Часто симулируют опухоль слюнной железы!

Сиалоз • Гипертрофия серозных ацинарных клеток с избытком мукойда • Отек интерстиция • Этиология: гормональные нарушения, цирроз печени, алкоголизм, алиментарные нарушения • Исход: липоматоз слюнной железы



Онкоцитоз • Эозинофильная зернистость в цитоплазме ацинарных клеток – онкоциты • Этиология не ясна • Усиленный обмен биогенных аминов • Возможное извращенное проявление патологической регенерации


Опухоли слюнных желез

Общие представления • Слюнные железы эмбриологически «сложный» орган • Вопрос гистогенеза многих опухолей слюнных желез не вполне ясен • Проблема катаплазии в ходе онкогенеза • Морфологическая диагностика сложная и комплексная • Классификация продолжает разрабатываться


Слюнные железы • Ацинус – ацинарные и миоэпителиальные клетки • Вставочный проток – эпителиальные, миоэпителиальные и резервные клетки • Исчерченный проток – эпителиальные клетки и онкоциты • Междольковый проток – эпителиальные клетки выводных протоков

Основные клетки слюнных желез • • Цилиндрические Бокаловидные Плоские Онкоциты Ацинарные Миоэпителиальные Резервные клетки

Аденомы • • • Плеоморфная аденома Миоэпителиома Базальноклеточная аденома Опухоль Уортона (аденолимфома) Онкоцитома (онкоклеточная аденома) Другие аденомы

Плеоморфная аденома • • • Синоним: смешанная опухоль Первое место по встречаемости Чаще в возрасте 50 -60 лет Несколько чаще женщины 75% случаев большие слюнные железы

Плеоморфная аденома Макро- Микро- • Плотный узел • До 5 см в диаметре • Серого цвета с ослизнением • Имеются участки хрящеподобной плотности • Тубулярно-трабекулярная с миксойдным компонентом • Тубулярно-трабекулярная с хондройдным компонентом • Солидный вариант





Особенности рецидивов Макро- Микро- • Узел или группа узлов мягкой консистенции с ослизнением • Тубулярно-трабекулярный вариант с выраженным миксойдным компонентом

Миоэпителиома • Выделена относительно недавно из плеоморфной аденомы • Встречается редко • Чаще поражается околоушная железа • Растет медленно • Безболезненна

Миоэпителиома Макро- Микро- • Неправильной формы узел • Ретикулярная с миксойдным • Белесоватая на разрезе компонентом • Солидный тип • Смешанная форма

Опухоль Уортона • Синонимы: аденолимфома, папиллярная лимфоматозная цистоаденома • Второе место по встречаемости • Возникает исключительно в околоушных железах • Чаще мужчины • Иногда двухсторонняя

Опухоль Уортона Макро- Микро- • Бледно-серый узел • На разрезе множество мелких кист с серозным содержимым • Железистые и кистозные структуры выстланы двойным слоем клеток • В строме имеется лимфойдная ткань




Онкоцитома • • Встречается редко Чаще околоушная железа Чаще 60 -80 лет Встречаются многофокусные и двухсторонние поражения

Онкоцитома Макро- Микро- • Узел с четкими границами • Эластической консиситенции • Окружен капсулой • На разрезе бурого цвета • Крупные светлые клетки с зернистой цитоплазмой и небольшим ядром • Формирование альвеолярно-солидных структур




Рак слюнных желез

Рак слюнных желез Мукоэпидермойдный рак Аденокистозный рак Карцинома в плеоморфной аденоме Эпителиально-миоэпителиальная карцинома • Ациноклеточная карцинома • Редкие типы (папиллярный, кистозный, фолликулярный и т. д. ) • •

Мукоэпидермойдный рак • Женщины 50 -60 лет • Околоушная железа • Нередко возникает на небе из малых слюнных желез • Склонен к инвазии и метастазированию лимфогенным путем не зависимо от степени дифференцировки

Мукоэпидермойдный рак Макро- • • • Хорошо ограничен Капсула неполная Множественные кисты Плотность неоднородная Цвет желто-серый Размерами до 4 см в диаметре Микро- • Картина неоднородна • Кисты • Слизь секретирующие клетки • Эпидермойдные клетки • Часто требуется ИГХ исследование


Аденокистозный рак • Синонимы: аденоидкистозный, цилиндрома • Второй по частоте рак слюнных желез • Чаще женщины 60 -70 лет • Часто мелкие слюнные железы • Характерен инвазивный рост по ходу нервов и болевой синдром • Опухоль крайне злокачественная

Аденокистозный рак Макро- Микро- • Границы не четкие • Серого цвета • До 4 см в диаметре • Не выражен клеточный атипизм • Характерно наличие мелких кист • Криброзный • Тубулярный • Солидный


Карцинома в плеоморфной аденоме • • Третья по частоте встречаемости Делится на инвазивную и неинвазивную Пик встречаемости 40 лет Локализация околоушная и поднижнечелюстная железы

Карцинома в плеоморфной аденоме Макро- Микро- • Узел или конгломерат узлов бело-серого цвета • Диаметром до 3 см • Плотной консистенции • Участки аденокистозной карциномы, мукоэпидермойдной карциномы, аденокарциномы и. т. д. • Некрозы • Кровоизлияния • Гиалиноз стромы


Эпителиально-миоэпителиальная карцинома Описана в 1972 году Donath K. Чаще женщины Чаще 70 -80 лет Чаще околоушная железа Отличается инвазивным ростом и рецидивами • Дает метастазы в шейные лимфоузлы • • •

Эпителиально-миоэпителиальная карцинома Макро- Микро- • Узел неправильной формы • Границы стерты • Бывает конгломерат узлов • Состоит из двух типов клеток • Тубулярный тип • Солидный тип • Склерозирующий тип • Имеются признаки атипии несмотря на сложное строение

Ациноклеточная карцинома • Прошла сложный путь по расположению в классификации • Встречается нечасто • Чаще женщины • Возрастной пик до конца не ясен • Чаще околоушная железа • Узел медленно растет, болезненный

Ациноклеточная карцинома Макро- Микро- • Плотный серый узел до 1 см в диаметре • Имеется капсула • Светлые зернистые клетки • Напоминают серозные клетки ацинусов • Солидный тип • Микрокистозный тип • Гиалиноз стромы

Спасибо за внимание!
Лекция болезни слюнных желез Литвинов.pptx